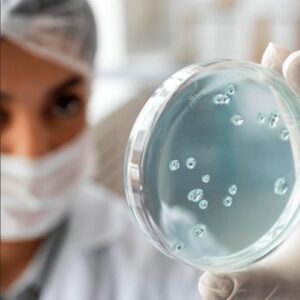

🇺🇸 Key Natural Ingredients in UltraK9 Pro and Their Benefits
UltraK9 Pro is made from high-quality, natural ingredients selected for their ability to restore your dog’s health in a primal, effective way. Here are some of the key components:
Ashwagandha
A powerful adaptogen that helps reduce stress, balance hormones, and boost overall energy.Ginseng Root
Strengthens the immune system and improves vitality — great for older dogs that have lost their spark.Astragalus
Supports detoxification and protects vital organs like the liver and kidneys.Licorice Root
Soothes digestive issues and acts as a natural anti-inflammatory, especially for joints.Dandelion
Rich in antioxidants and fiber, it aids digestion and supports liver health.Milk Thistle
One of the most effective liver protectors — essential for dogs exposed to years of commercial food.Ginger Root
Eases nausea, enhances digestion, and improves circulation — helping your dog feel more active and alert.
Each ingredient was carefully chosen as part of a “wild dog menu”, reconnecting your dog to the nutrients nature intended.